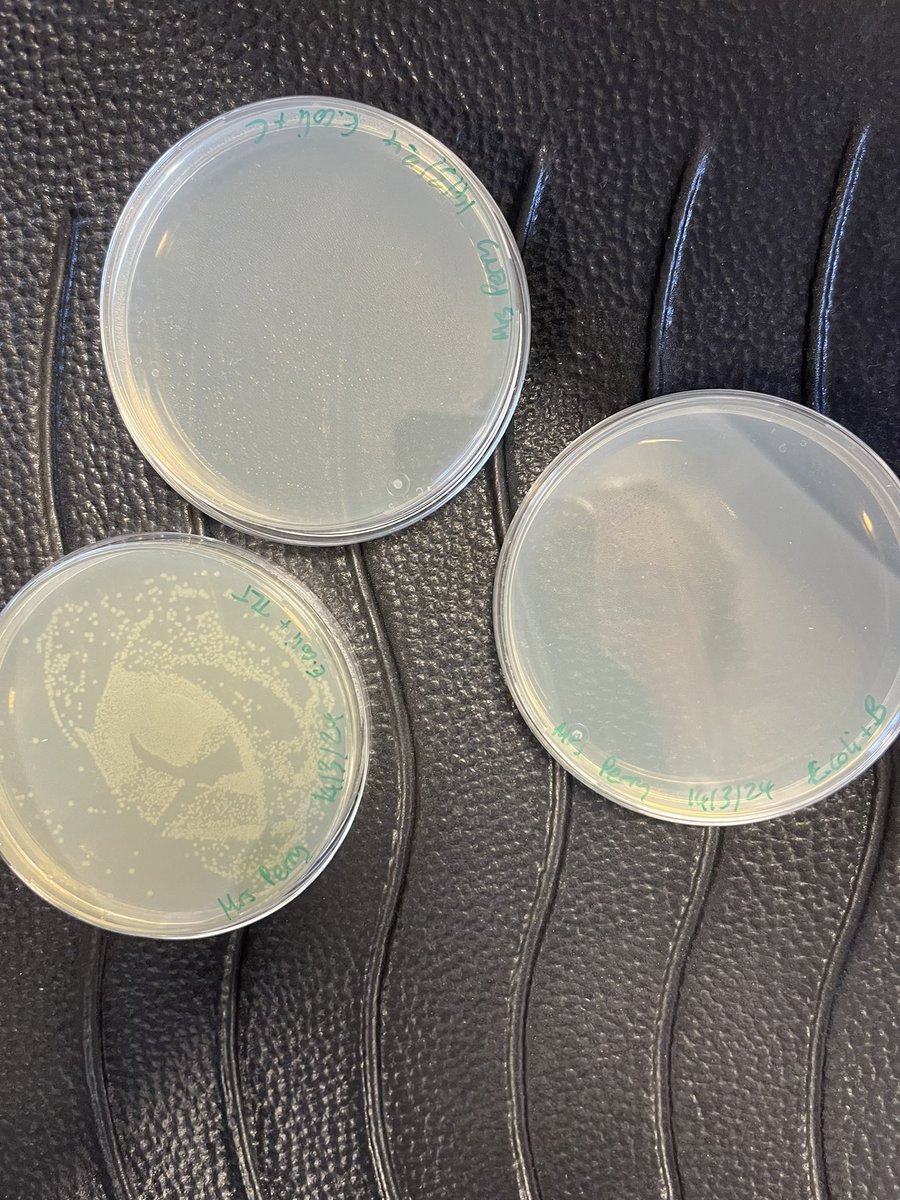
CroxleyScience's tweet image. We also got to see our dilution plates and plasmid bacterial transformation plates! A few of us managed to replicate enough plasmid for Dr McKinnon to use in his lab!
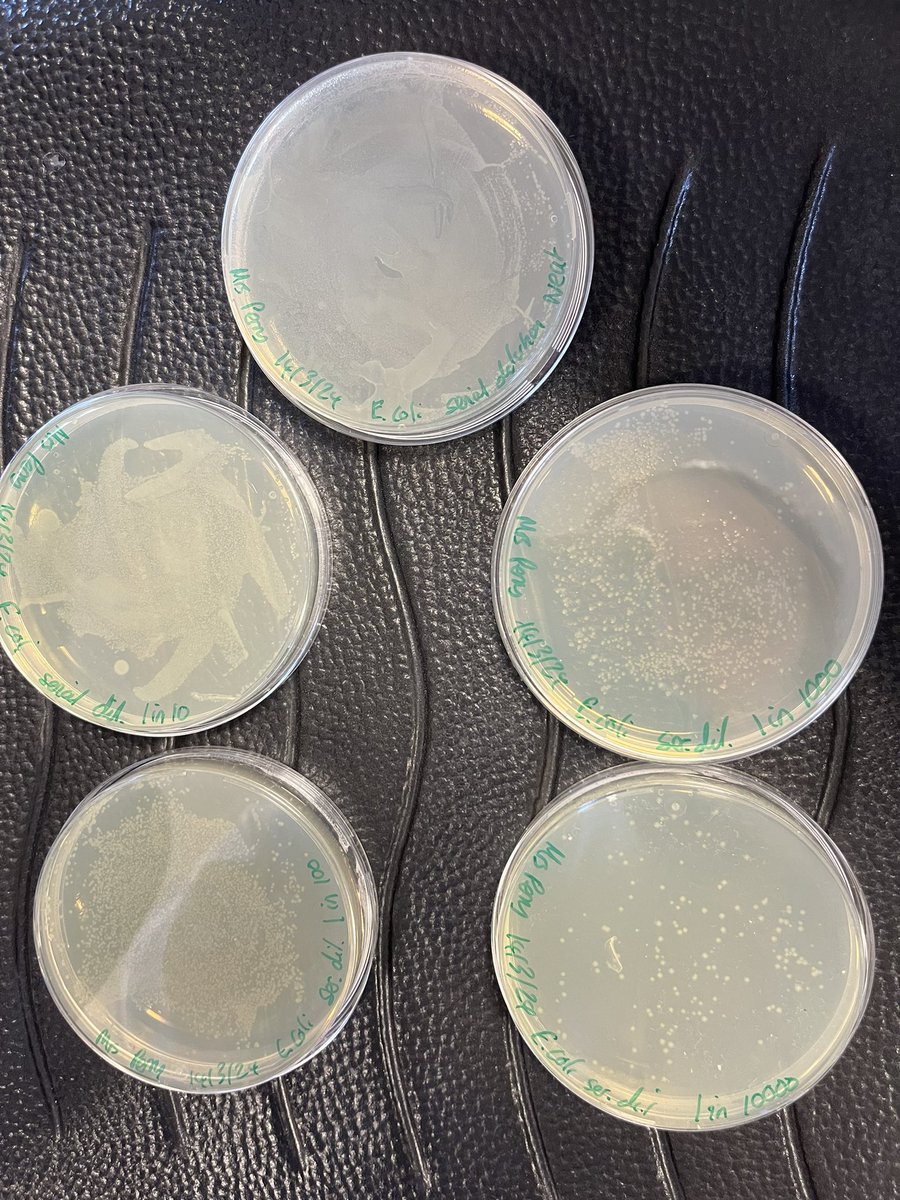
CroxleyScience's tweet image. We also got to see our dilution plates and plasmid bacterial transformation plates! A few of us managed to replicate enough plasmid for Dr McKinnon to use in his lab!

CDSSixthForm
@CDSsixthform
The Sixth Form twitter feed from Croxley Danes School. Follow us to see Sixth Form news and posts from the huge world of careers and higher education!
Dit vind je misschien leuk
Welcome to the Croxley Sixth Form page. Watch this space for the latest news and updates as we introduce our very first sixth formers at Croxley Danes School.

Heading towards Computer Science is this amazing set of results from one of our outgoing first ever @croxleydanes Head Students. We are very proud of all your achievements here and good luck 👏👏👏

This @croxleydanes Sixth Former is off to Malaysia to study medicine - we’re going to need a worldwide first ever destinations map! Really well done and good luck 👏👏👏

This @croxleydanes Year 13 is off to City uni, London to study Law. We are proud of your achievement - the best of luck! 👏👏👏

A brilliant set of results for this @croxleydanes senior student - we are proud of your achievement 👏👏👏

Fantastic results for this @croxleydanes Sixth Former from our first ever results day - off to first choice Leicester University 👏👏👏

Computing with AI and Product Design are the destinations for these two @croxleydanes Year 13 leavers - congrats!

A group of @croxleydanes Year 13s from our inaugural cohort are heading off to fantastic universities and courses 👏👏👏

Already at work, this @croxleydanes Year 13 leaver is learning his trade as a chef in a 5 star hotel restaurant. Well done and hopefully we can sample this one day!

Our first ever Sixth Former to have enrolled 2 years ago @croxleydanes is off to University of Nottingham to study Politics and Economics with great results. Well done!

We’re shortly opening the doors to @croxleydanes first ever A-level results day and look forward to celebrating and helping our inaugural cohort with their next steps. We are very proud of an amazing group of resilient students who will leave a great legacy!

Huge thanks to @speakrs4schools and David Dein for his inspirational talk to our @croxleydanes Year 12 students and successful girls' football team last week - full report here ➡️ croxleydanes.org.uk/190/news-and-e…

Fantastic day's oracy training from @talkthetalkUK with our @DanesEdTrust new senior students from the Year 12s of @croxleydanes @OnslowStAudreys @ChancellorsSch @SCDSchool @johnwarnersch @esa_learning - well done all - this group are going to be awesome student leaders! 👏 👏👏




⭐ Workshops still available ⭐ stressed about exams or know someone who is? Our team are here to help 🙂 They're providing exam stress workshops at their Watford, Hemel + Stevenage locations on the 11th, 13th and 18th May 📆 To sign up, contact [email protected] 📧

Following a rigorous voting process across staff, Y12 students and SLT, we are delighted to announce our new team of Head Students for 2024/25. Huge congratulations to Head Students, Bibibella M & Jake B & Deputy Head Students Nevaeh R and Lucy P on this tremendous achievement!
The class of 2024 and the first ever Year 13 leavers @croxleydanes - Friday saw a fantastic last day's celebrations with speeches, pizza and a trip to our local Paintball centre. We wish them the very best of luck in their exams and next steps.

Chat to students who are already studying at the universities you've applied to, for advice on accommodation, student life, and more: bit.ly/3W2ZYLC

Student Finance update for @croxleydanes university applicants in Year 13 from our colleagues at @UniofHerts - Student finance is now open for 2024 entry: start your application by going to gov.uk/apply-online-f…. Uni Herts videos to help all: shorturl.at/ekoHX

Exciting news! 🎉 Herts is launching eight new degree apprenticeships thanks to securing £1.25 million in funding. This initiative will open up incredible opportunities for students to combine work and study, paving the way for successful careers. bit.ly/4agR2pS
We also got to see our dilution plates and plasmid bacterial transformation plates! A few of us managed to replicate enough plasmid for Dr McKinnon to use in his lab!

A huge thank you to Dr McKinnon and his team at @imperialcollege for a really fun, packed 2 days. We all enjoyed it very much!

United States Trends
- 1. Thanksgiving 146K posts
- 2. #IDontWantToOverreactBUT 1,314 posts
- 3. #GEAT_NEWS 1,420 posts
- 4. Jimmy Cliff 24.2K posts
- 5. #WooSoxWishList 2,232 posts
- 6. #MondayMotivation 13.5K posts
- 7. #NutramentHolidayPromotion N/A
- 8. DOGE 233K posts
- 9. $ENLV 18.8K posts
- 10. Victory Monday 4,385 posts
- 11. TOP CALL 5,006 posts
- 12. Monad 173K posts
- 13. Good Monday 52.2K posts
- 14. Justin Tucker N/A
- 15. Feast Week 1,996 posts
- 16. The Harder They Come 3,664 posts
- 17. $GEAT 1,316 posts
- 18. $MON 34K posts
- 19. AI Alert 3,070 posts
- 20. Soles 101K posts
Something went wrong.
Something went wrong.





































































































